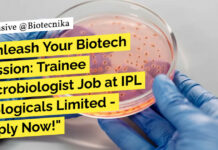
Trainee Microbiologist QC Job

Home 2024
Yearly Archives: 2024
CSIR-IGIB Biotech & Microbiology Project Scientist Position – Apply Online
CSIR-IGIB Project Scientist Position For Biotech & Microbiology - Apply Online
CSIR-IGIB Project Scientist Position For Biotech & Microbiology - Apply Online. Interested and eligible...
Life Science Positions at AIIMS New Delhi – Apply Now!
Life Science Positions at AIIMS New Delhi - Apply Now!
DEPARTMENT OF PHARMACOLOGY
ALL INDIA INSTITUTE OF MEDICAL SCIENCES
New Delhi 110029
DATE: 18/09/2024
Applications are invited for the...
IIT Gandhinagar PhD Admission 2024-25 (Sem II) Biological Sciences and Engineering
IIT Gandhinagar PhD Admissions 2024-25 Biological Sciences and Engineering
IIT Gandhinagar PhD Admissions 2024-25 Biological Sciences and Engineering. IIT Gandhinagar PhD Admissions 2024-25 Biological Engineering....
Freshers Jobs In Agriculture at Advanta Seeds! Apply Online
Freshers Jobs In Agriculture at Advanta Seeds! Apply Online
Executive - Field Quality
Job Id: 9852
City: Nandyal, Andhra Pradesh, India
Department: SCM
Function: SCM
Employee Type: Permanent Full Time
Seniority...
BE Biotechnology QC Engineer Role at Merck, Apply Online
Biotechnology QC Engineer Role at Merck, Apply Online
QC Engineer
Job Id 279495
Bangalore, Karnataka, India
Job Type: Full-time
Work Your Magic with us!
Ready to explore, break barriers, and...
Exciting Trainee Microbiologist QC Opportunity at IPL Biologicals Limited – Apply Now!
Trainee Microbiologist QC Job at IPL Biologicals Limited - Apply Now!
IPL Biologicals Limited
Trainee Microbiologist - QC
Location: Haridwar, Uttarakhand, India
About the Job
Must have experience...
Quality Assurance Manager at iD Fresh Food – Apply Now!
Quality Assurance Manager at iD Fresh Food - Apply Now!
Quality Assurance Manager
Location: Bengaluru, Karnataka, India
About the Job
About iD Fresh Food
iD Fresh Food’s mission is...
Hiring Freshers & Experienced For Customer Satisfaction Officer Post @ Biotecnika – Apply Online
Life Science Career Opportunities
BioTecNika Info Labs Pvt Ltd runs India’s Largest Biosciences Career & Education Portal and is looking for passionate candidates with sound...
NCCS Pune Short-Term Trainee Internship With Monthly Emoluments – Applications Invited
NCCS Short-Term Trainee Internship With Monthly Emoluments - Applications Invited
NATIONAL CENTRE FOR CELL SCIENCE, PUNE
(An autonomous Institution of the Department of Biotechnology, Government of...
Bioinformatics & AI ML Researcher & Trainer Job Opening at Biotecnika, Bangalore – Attractive...
Bioinformatics Researcher & Trainer Job
Biotecnika is a renowned entity in the BIO-IT sector, backed by biotech veterans and venture capitalists. We're committed to innovation...
Biotecnika Times Newsletter 19.09.2024 – Freshers Life Sciences Jobs at GSK, CDFD PhD, Clini...
Freshers Literature Specialist Intern at GSK - Apply Now!
GSK is hiring a Literature Specialist Intern. This is a fantastic opportunity for those looking to...
CDFD PhD-I-2025 Admission for Research Scholars Program – Apply Online
CDFD PhD-I-2025 Admission for Research Scholars Program - Apply Online
Centre for DNA Fingerprinting and Diagnostics
INNER RING ROAD, UPPAL, HYDERABAD - 500 039
(www.cdfd.org.in)
PhD-I-2025 Admissions
The Centre...
Exciting Job Opportunities at C-CAMP Discovery to Innovation Accelerator (DIA) For Life Sciences –...
C-CAMP Life Sciences Vacancies - Translation & Post Scientist Roles
Centre for Cellular and Molecular Platforms (C-CAMP), is a Dept. of Biotechnology (Govt. of India)...
SURPRISE! Get Paid Rs. 56,000/month to Research Bioinformatics at Bose Institute, Kolkata!
Research Bioinformatics at Bose Institute, Kolkata! Apply Now
ADVT. No. S/BIO/13/2024-25
Bose Institute, Kolkata, invites applications from Indian Citizens for one temporary position of Project Scientist...
Exciting Project Associate Job Opportunity at TERI Energy! MSc Biotech Apply Online
Project Associate Job Opportunity at TERI Energy! MSc Biotech Apply Online
Sustainable Agriculture
Project Associate (Consultant)
Job Profile
Establish natural product extraction, isolation, separation, and purification pipelines...